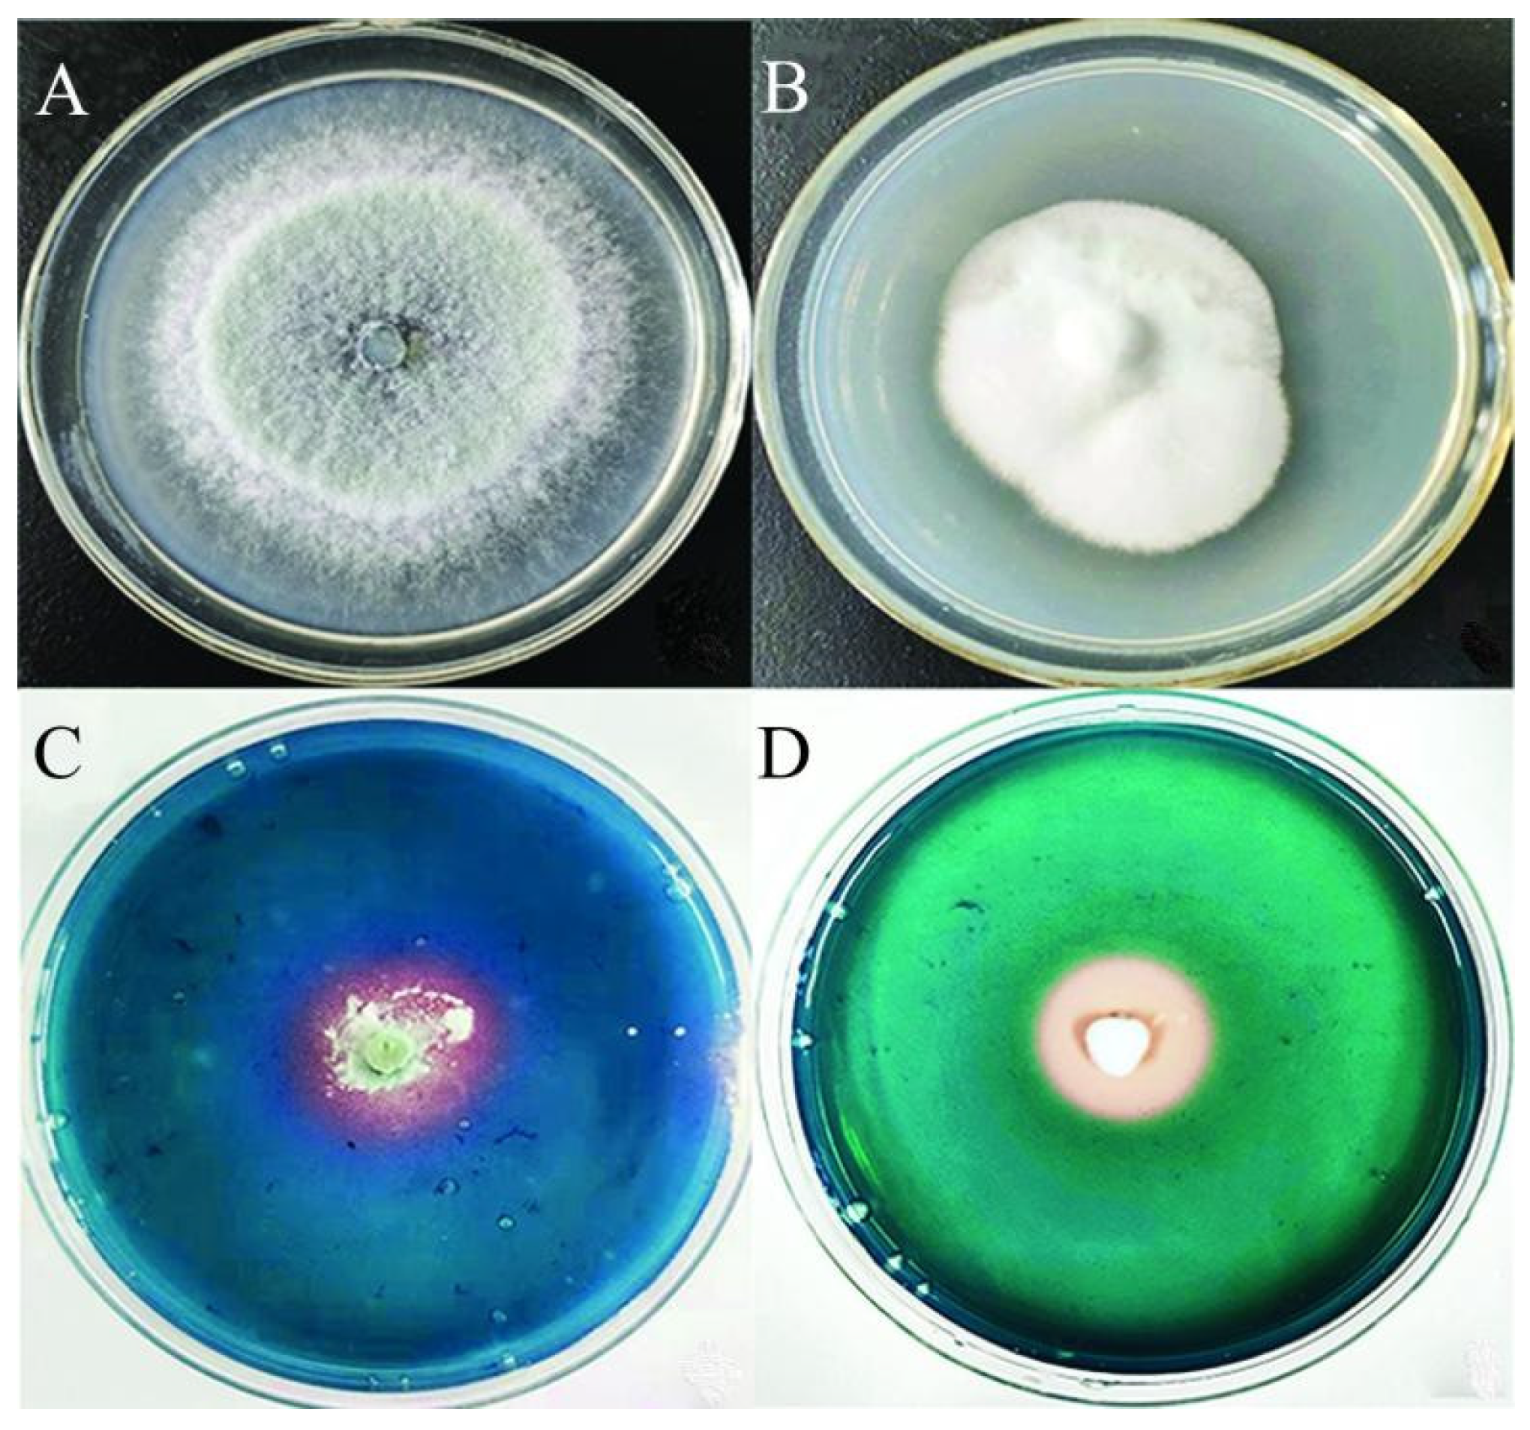
Microorganisms 11 01535 g002

Differential Responses of Bacterial and Fungal Communities to Siderophore Supplementation in Soil Affected by Tobacco Bacterial Wilt (Ralstonia solanacearum)
Abstract
1. Introduction
2. Material and Methods
2.1. Sample Sources
2.2. Fungal Strains with a High Yield of Siderophore
2.3. Preparation of the Test Solution and Culture Medium
2.4. Morphological Observation and Molecular Characterization
2.5. Determination of Secretory Activity and Type Identification of Siderophore
2.6. Separation of Siderophore
2.7. Treatment of TBW Soil
2.8. DNA Extraction, Illumina MiSeq High-Throughput Sequencing, and Bioinformatics/Statistical Analysis
2.9. Soil Sucrase/Urease Activities and Soil Biolog
3. Results
3.1. Field Investigation of TBW and Siderophore-Producing Strains
3.2. Strain Morphology and Molecular Characterization
3.3. Alpha Diversity of Soil Microbial Community
3.4. Beta Diversity of Soil Microbial Community
3.5. Microbial Community Structure Impacted by Siderophore Treatment
3.6. Enzyme Abundance of Soil Microbial Community
3.7. BugBase Phenotypic Prediction
3.8. Effect of Siderophore on Enzyme Activity of TBW Soil
3.9. Effects of Siderophores on Carbon Source Utilization of TBW Soil
4. Discussion
Supplementary Materials
Author Contributions
Funding
Data Availability Statement
Conflicts of Interest
References
- Colombo, C.; Palumbo, C.; He, J.Z.; Pinton, R.; Cesco, S. Review on iron availability in soil: Interaction of Fe minerals, plants, and microbes. J. Soils Sediments 2014, 14, 538–548. [Google Scholar] [CrossRef]
- Hu, Y.; Li, Y.Y.; Yang, X.Q.; Li, C.L.; Wang, L.; Feng, J.; Chen, S.W.; Li, X.H.; Yang, Y. Effects of integrated biocontrol on bacterial wilt and rhizosphere bacterial community of tobacco. Sci. Rep. 2021, 11, 2653. [Google Scholar] [CrossRef] [PubMed]
- Yuan, S.F.; Li, M.Y.; Fang, Z.Y.; Liu, Y.; Shi, W.; Pan, B.; Wu, K.; Shi, J.X.; Shen, B.; Shen, Q.R. Biological control of tobacco bacterial wilt using Trichoderma harzianum amended bioorganic fertilizer and the arbuscular mycorrhizal fungi Glomus mosseae. Biol. Control 2016, 92, 164–171. [Google Scholar] [CrossRef]
- Mendes, R.; Garbeva, P.; Raaijmakers, J.M. The rhizosphere microbiome: Significance of plant beneficial, plant pathogenic, and human pathogenic microorganisms. FEMS Microbiol. Rev. 2013, 37, 634–663. [Google Scholar] [CrossRef] [PubMed]
- Viczian, O.; Kunstler, A.; Hafez, Y.; Kiraly, L. Catalases may play different roles in influencing resistance to virus-induced hypersensitive necrosis. Acta Phytopathol. Entomol. Hung. 2014, 49, 189–200. [Google Scholar] [CrossRef]
- Cai, L.; Chen, J.N.; Liu, Z.W.; Wang, H.C.; Yang, H.K.; Ding, W. Magnesium oxide nanoparticles: Effective agricultural antibacterial agent against Ralstonia solanacearum. Front. Microbiol. 2018, 9, 790. [Google Scholar] [CrossRef] [PubMed]
- Shigemoto-Mogami, Y.; Fujimori, K.; lkarashi, Y.; Hirose, A.; Sekino, A.; Sato, K. Residual metals in carbon nanotubes suppress the proliferation of neural stem cells. Fundam. Toxicol. Sci. 2014, 1, 87–94. [Google Scholar] [CrossRef]
- Qin, C.; Chen, C.Q.; Shang, C.; Xia, K. Fe3+-saturated montmorillonite effectively deactivates bacteria in wastewater. Sci. Total Environ. 2018, 622, 88–95. [Google Scholar] [CrossRef] [PubMed]
- Kim, D.H.; Lee, D.W.; Monllor-Satoca, D.; Kim, K.; Lee, W.J.; Choi, W.Y. Homogeneous photocatalytic Fe3+/Fe2+ redox cycle for simultaneous Cr (VI) reduction and organic pollutant oxidation: Roles of hydroxyl radical and degradation intermediates. J. Hazard. 2019, 372, 121–128. [Google Scholar] [CrossRef] [PubMed]
- Rudin, D.; Lanzilotto, A.; Bachmann, F.; Housecroft, C.E.; Constable, E.C.; Drewe, J.; Haschke, M.; Krahenbihl, S. Non-immunological toxicological mechanisms of metamizole-associated neutropenia in HL60 cells. Biochem. Pharmacol. 2019, 163, 345–356. [Google Scholar] [CrossRef]
- Singh, P.; Chauhan, P.K.; Upadhyay, S.K.; Singh, R.K.; Dwivedi, P.; Wang, J.; Jain, D.; Jiang, M.G. Mechanistic insights and potential use of siderophores producing microbes in rhizosphere for mitigation of stress in plants grown in degraded land. Front. Microbiol. 2022, 13, 898979. [Google Scholar] [CrossRef] [PubMed]
- Gledhill, M.; McCormack, P.; Ussher, S.; Achterberg, E.P.; Mantoura, R.F.C.; Worsfold, P.J. Production of siderophore type chelates by mixed bacterioplankton populations in nutrient enriched seawater incubations. Mar. Chem. 2004, 88, 75–83. [Google Scholar] [CrossRef]
- Guo, D.S.; Yuan, C.H.; Luo, Y.Y.; Chen, Y.H.; Lu, M.H.; Chen, G.C.; Ren, G.W.; Cui, C.B.; Zhang, J.T.; An, D.R. Biocontrol of tobacco black shank disease (Phytophthora nicotianae) by Bacillus velezensis Ba168. Pestic. Biochem. Physiol. 2020, 165, 104523. [Google Scholar] [CrossRef] [PubMed]
- Solanki, M.K.; Singh, R.K.; Srivastava, S.; Kumar, S.; Kashyap, P.L.; Srivastava, A.K.; Arora, D.K. Isolation and characterization of siderophore producing antagonistic rhizobacteria against Rhizoctonia solani. J. Basic Microbiol. 2014, 54, 585–597. [Google Scholar] [CrossRef] [PubMed]
- Masum, M.M.I.; Liu, L.; Yang, M.; Hossain, M.M.; Siddiqa, M.M.; Supty, M.E.; Ogunyemi, S.O.; Hossain, A.; An, Q.; Li, B. Halotolerant bacteria belonging to operational group Bacillus amyloliquefaciens in biocontrol of the rice brown stripe pathogen Acidovorax oryzae. J. Appl. Microbiol. 2018, 125, 1852–1867. [Google Scholar] [CrossRef]
- Fgaier, H.; Eberl, H.J. Antagonistic control of microbial pathogens under iron limitations by siderophore producing bacteria in a chemostat setup. J. Theor. Biol. 2011, 273, 103–114. [Google Scholar] [CrossRef]
- Retamal-Morales, G.; Mehnert, M.; Schwabe, R.; Tischler, D.; Zapata, C.; Chvez, R.; Schlömann, M.; Levicán, G. Detection of arsenic-binding siderophores in arsenic-tolerating Actinobacteria by a modified CAS assay. Ecotoxicol. Environ. Saf. 2018, 157, 176–181. [Google Scholar] [CrossRef]
- Albelda-Berenguer, M.; Monachon, M.; Joseph, E. Siderophores: From natural roles to potential applications. Adv. Appl. Microbiol. 2019, 106, 193–225. [Google Scholar] [CrossRef]
- Wang, J.T.; Peng, J.; Zhao, M.Y.; Liu, Y.X.; Chen, Y.Q. Significant trade-off for the impact of Grain-for-Green Programme on ecosystem services in North-western Yunnan, China. Sci. Total Environ. 2017, 574, 57–64. [Google Scholar] [CrossRef]
- Miethke, M.; Marahiel, M.A. Siderophore-based iron acquisition and pathogen control. Microbiol. Mol. Biol. Rev. 2007, 71, 413–451. [Google Scholar] [CrossRef]
- Prasad, R.; Kumar, M.; Varma, A. Role of PGPR in soil fertility and plant health. In Plant-Growth-Promoting Rhizobacteria (PGPR) and Medicinal Plants; Springer: Berlin/Heidelberg, Germany, 2015; pp. 247–260. [Google Scholar] [CrossRef]
- Saha, M.; Sarkar, M.; Sarkar, B.; Sharma, B.K.; Bhattacharjee, S.; Tribedi, P. Microbial siderophores and their potential applications: A review. Environ. Sci. Pollut. Res. 2016, 23, 3984–3999. [Google Scholar] [CrossRef] [PubMed]
- Lu, R.K. Methods for Agricultural Chemical Analysis of Soil; China Agricultural Science and Technology Press: Beijing, China, 1999. [Google Scholar]
- Brandenburger, E.; Gressler, M.; Leonhardt, R.; Lackner, G.; Habel, A.; Hertweck, C.; Matthias, B.; Dirk, H. A highly conserved basidiomycete peptide synthetase produces a trimeric hydroxamate siderophore. Appl. Environ. Microbiol. 2017, 83, e01478-17. [Google Scholar] [CrossRef] [PubMed]
- Pan, X.Q.; Welti, R.; Wang, X.M. Quantitative analysis of major plant hormones in crude plant extracts by high-performance liquid chromatography-mass spectrometry. Nat. Protoc. 2010, 5, 986–992. [Google Scholar] [CrossRef] [PubMed]
- Ma, L.; Zhang, H.Y.; Zhou, X.K.; Yang, C.G.; Zheng, S.C.; Duo, J.L.; Mo, M.H. Biological control tobacco bacterial wilt and black shank and root colonization by bio-organic fertilizer containing bacterium Pseudomonas aeruginosa NXHG29. Appl. Soil Ecol. 2018, 129, 136–144. [Google Scholar] [CrossRef]
- Machuca, A.; Milagres, A.M.F. Use of CAS-agar plate modified to study the effect of different variables on the siderophore production by Aspergillus. Lett. Appl. Microbiol. 2003, 36, 177–181. [Google Scholar] [CrossRef] [PubMed]
- Sah, S.; Singh, N.; Singh, R. Iron acquisition in maize (Zea mays L.) using Pseudomonas siderophore. 3 Biotech. 2017, 7, 121. [Google Scholar] [CrossRef]
- Chen, L.H.; Lin, C.H.; Chung, K.R. A nonribosomal peptide synthetase mediates siderophore production and virulence in the citrus fungal pathogen Alternaria alternata. Mol. Plant Pathol. 2013, 14, 497–505. [Google Scholar] [CrossRef]
- Toscano-Verduzco, F.A.; Cedeno-Valdivia, P.A.; Chan-Cupul, W.; Hernandez-Ortega, H.A.; Ruiz-Sanchez, E.; Galindo-Velasco, E.; Cruz-Crespo, E. Phosphates solubilization, indol-3-acetic acid and siderophores production by Beauveria brongniartii and its effect on growth and fruit quality of Capsicum chinense. J. Hortic. Sci. Biotechnol. 2020, 95, 235–246. [Google Scholar] [CrossRef]
- Jirakkakul, J.; Cheevadhanarak, S.; Punya, J.; Chutrakul, C.; Senachak, J.; Buajarern, T.; Tanticharoen, M.; Amnuaykanjanasin, A. Tenellin acts as an iron chelator to prevent iron-generated reactive oxygen species toxicity in the entomopathogenic fungus Beauveria bassiana. FEMS Microbiol. Lett. 2015, 362, 1–8. [Google Scholar] [CrossRef] [PubMed]
- Zhao, L.; Wang, Y.; Kong, S. Effects of Trichoderma asperellum and its siderophores on endogenous auxin in Arabidopsis thaliana under iron-deficiency stress. Int. Microbiol. 2020, 23, 501–509. [Google Scholar] [CrossRef]
- Vinale, F.; Nigro, M.; Sivasithamparam, K.; Ghisalberti, G.F.E.L.; Ruocco, M.; Varlese, R.; Marra, R.; Lanzuise, S.; Eid, S.; Woo, S.L.; et al. Harzianic acid: A novel siderophore from Trichoderma harzianum. FEMS Microbiol. Lett. 2013, 347, 123–129. [Google Scholar] [CrossRef] [PubMed]
- Mukherjee, P.K.; Hurley, J.F.; Taylor, J.T.; Puckhaber, L.; Lehner, S.; Druzhinina, L.; Schumacher, S.; Kenerley, C.M. Ferricrocin, the intracellular siderophore of Trichoderma virens, is involved in growth, conidiation, gliotoxin biosynthesis and induction of systemic resistance in maize. Biochem. Bioph. Res. Commun. 2018, 505, 606–611. [Google Scholar] [CrossRef] [PubMed]
- Chadha, N.; Prasad, R.; Varma, A. Plant promoting activities of fungal endophytes associated with tomato roots from Central Himalaya, India and their interaction with Piriformospora indica. Int. J. Pharma Bio Sci. 2015, 6, 333–343. [Google Scholar]
- Ahmed, E.; Holmström, S.J.M. Siderophores in environmental research: Roles and applications. Microb. Biotechnol. 2014, 7, 196–208. [Google Scholar] [CrossRef] [PubMed]
- Korpany, K.V.; Majewski, D.D.; Chiu, C.T.; Cross, S.N.; Blum, A.S. Iron oxide surface chemistry: Effect of chemical structure on binding in benzoic acid and catechol derivatives. Langmuir 2017, 33, 3000–3013. [Google Scholar] [CrossRef]
- Khan, A.; Singh, P.; Srivastava, A. Synthesis, nature and utility of universal iron chelator–Siderophore: A review. Res. Microbiol. 2018, 212, 103–111. [Google Scholar] [CrossRef]
- Ambrosi, C.; Leoni, L.; Putignani, L.; Orsi, N.; Visca, P. Pseudobactin biogenesis in the plant growth-promoting rhizobacterium Pseudomonas strain B10: Identification and functional analysis of the L-ornithine N5-oxygenase (psbA) gene. J. Bacteriol. 2000, 182, 6233–6238. [Google Scholar] [CrossRef]
- Khasheii, B.; Mahmoodi, P.; Mohammadzadeh, A. Siderophores: Importance in bacterial pathogenesis and applications in medicine and industry. Microbiol. Res. 2021, 250, 126790. [Google Scholar] [CrossRef]
- Dutta, S.; Yu, S.M.; Jeong, S.C.; Lee, Y.H. High-throughput analysis of genes involved in biocontrol performance of Pseudomonas fluorescens NBC275 against Gray mold. J. Appl. Microbiol. 2020, 128, 265–279. [Google Scholar] [CrossRef]
- Miransari, M. Soil microbes and plant fertilization. Appl. Microbiol. Biotechnol. 2011, 92, 875–885. [Google Scholar] [CrossRef]
- Lin, W.P.; Jiang, N.H.; Li, P.; Fan, X.Y.; Gao, Y.; Wang, G.P.; Cai, K.Z. Silicon impacts on soil microflora under Ralstonia Solanacearum inoculation. J. Integr. Agric. 2020, 19, 251–264. [Google Scholar] [CrossRef]
- Xue, H.; Lozano-Duran, R.; Macho, A.P. Insights into the root invasion by the plant pathogenic bacterium Ralstonia solanacearum. Plants 2020, 9, 516. [Google Scholar] [CrossRef] [PubMed]
- Butaite, E.; Baumgartner, M.; Wyder, S.; Kummerli, R. Siderophore cheating and cheating resistance shape competition for iron in soil and freshwater Pseudomonas communities. Nat. Commun. 2017, 8, 414. [Google Scholar] [CrossRef]
- Ghazy, N.; El-Nahrawy, S. Siderophore production by Bacillus subtilis MF497446 and Pseudomonas koreensis MG209738 and their efficacy in controlling Cephalosporium maydis in maize plant. Arch. Microbiol. 2021, 203, 1195–1209. [Google Scholar] [CrossRef] [PubMed]
- Voß, B.; Kirschhöfer, F.; Brenner-Weiß, G.; Fischer, R. Alternaria alternata uses two siderophore systems for iron acquisition. Sci. Rep. 2020, 10, 3587. [Google Scholar] [CrossRef] [PubMed]

| Index | CK | 2-8F2A | 2-8F2B | 2-8F2C | 2-14F2A | 2-14F2B | 2-14F2C | |
|---|---|---|---|---|---|---|---|---|
| 16S rRNA | Observed species | 1586.6 (370.3) b | 2469.6 (86.4) a | 2347 (146.6) a | 2445 (139.9) a | 2435.6 (68.5) a | 2406.3 (131.5) a | 2384 (122.2) a |
| Shannon | 4.4 (0.4) b | 6.4 (0.05) a | 6.1 (0.4) a | 6.4 (0.05) a | 6.3 (0.06) a | 6.3 (0.1) a | 6.4 (0.09) a | |
| Chao1 | 2156.1 (463.7) b | 3334.2 (152.7) a | 3144.7 (149.6) a | 3262.7 (237.5) a | 3303 (130.1) a | 3295.5 (197.2) a | 3295.1 (218.9) a | |
| ITS | Observed species | 329.3 (83.6) a | 434.6 (25.4) a | 422.3 (89.5) a | 465 (52.8) a | 494 (33) a | 479.6 (99.6) a | 397.6 (59.6) a |
| Shannon | 3.4 (0.1) a | 3.3 (0.1) a | 3.2 (0.3) a | 3.2 (0.2) a | 3.5 (0.1) a | 3.4 (0.2) a | 2.9 (0.4) a | |
| Chao1 | 410.8 (137.8) a | 565.7 (16.2) a | 514.9 (147.2) a | 574.6 (87.3) a | 639.8 (23.4) a | 608.6 (85.1) a | 481.3 (69.7) a |
Disclaimer/Publisher’s Note: The statements, opinions and data contained in all publications are solely those of the individual author(s) and contributor(s) and not of MDPI and/or the editor(s). MDPI and/or the editor(s) disclaim responsibility for any injury to people or property resulting from any ideas, methods, instructions or products referred to in the content. |
© 2023 by the authors. Licensee MDPI, Basel, Switzerland. This article is an open access article distributed under the terms and conditions of the Creative Commons Attribution (CC BY) license (https://creativecommons.org/licenses/by/4.0/).
Share and Cite
Shen, Y.; Zhao, J.; Zou, X.; Shi, Z.; Liao, Y.; He, Y.; Wang, H.; Chen, Q.; Yang, P.; Li, M. Differential Responses of Bacterial and Fungal Communities to Siderophore Supplementation in Soil Affected by Tobacco Bacterial Wilt (Ralstonia solanacearum). Microorganisms 2023, 11, 1535. https://doi.org/10.3390/microorganisms11061535
Shen Y, Zhao J, Zou X, Shi Z, Liao Y, He Y, Wang H, Chen Q, Yang P, Li M. Differential Responses of Bacterial and Fungal Communities to Siderophore Supplementation in Soil Affected by Tobacco Bacterial Wilt (Ralstonia solanacearum). Microorganisms. 2023; 11(6):1535. https://doi.org/10.3390/microorganisms11061535
Chicago/Turabian StyleShen, Yunxin, Jiangyuan Zhao, Xuefeng Zou, Zhufeng Shi, Yongqin Liao, Yonghong He, Hang Wang, Qibin Chen, Peiweng Yang, and Minggang Li. 2023. "Differential Responses of Bacterial and Fungal Communities to Siderophore Supplementation in Soil Affected by Tobacco Bacterial Wilt (Ralstonia solanacearum)" Microorganisms 11, no. 6: 1535. https://doi.org/10.3390/microorganisms11061535
APA StyleShen, Y., Zhao, J., Zou, X., Shi, Z., Liao, Y., He, Y., Wang, H., Chen, Q., Yang, P., & Li, M. (2023). Differential Responses of Bacterial and Fungal Communities to Siderophore Supplementation in Soil Affected by Tobacco Bacterial Wilt (Ralstonia solanacearum). Microorganisms, 11(6), 1535. https://doi.org/10.3390/microorganisms11061535
